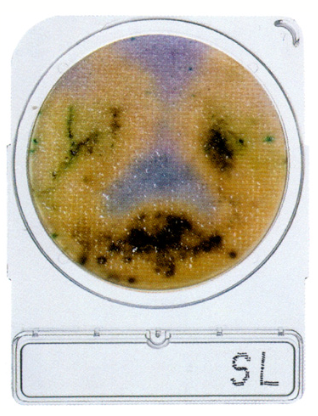
微生物快速测试片—沙门氏菌，Compact Dry SL 1400pc
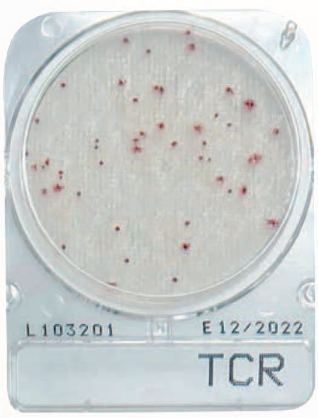
微生物快速测试片—菌落总数快速型，Compact Dry TCR 240pc

产品中心搜索
- 仪器部件与备件 (1)
- 液相色谱仪(HPLC)部件与备件 (882)
- 液相色谱质谱联用仪(LC/MS)部件与备件 (949)
- 气相色谱仪(GC)部件与备件 (669)
- 气相色谱质谱联用仪(GC/MS)部件与备件 (394)
-
光谱仪(UV、AA、ICP)部件与备件 (1724)
- UV-1900 (98)
- UV-1800 (106)
- UVmini-1285 (37)
- UV-1780 (103)
- UV-1750 (27)
- UV-2600/UV-2700 (91)
- UV-2450/UV-2550 (46)
- UV-3600/3600 Plus (120)
- UVmini-1280 (56)
- UV-1280 (86)
- UVmini-1240 (126)
- AA-6880 (176)
- AA-7000 (136)
- AA-6300/6300C (93)
- AA-6800 (43)
- AA-6650 (174)
- ICPE-9800/9820 (76)
- ICPS-8100 (75)
- ICPS-7510 (51)
- 红外相关 (4)
- 电感耦合等离子体质谱仪(ICP-MS)部件与备件 (32)
- 总有机碳分析仪(TOC)部件与备件 (197)
- 其他仪器部件与备件 (82)
- 液相色谱柱及保护柱 (2)
-
反相/正相/HILIC色谱柱 (71)
- ShimNex CS C18色谱柱 (2)
- ShimNex HE系列色谱柱 (17)
- ShimNex WP系列色谱柱 (5)
- ShimNex UP系列色谱柱 (3)
- ShimNex WR系列色谱柱 (2)
- Shim-pack Scepter系列杂化颗粒色谱柱 (9)
- Shim-pack G系列高纯硅胶色谱柱 (13)
- Shim-pack Velox系列实心核颗粒色谱柱 (5)
- Shim-pack Arata系列高纯硅胶色谱柱 (2)
- Shim-pack VP系列高纯硅胶色谱柱 (3)
- Shim-pack FC系列高纯硅胶色谱柱 (1)
- Shim-pack XR系列高纯硅胶色谱柱 (6)
- SHIMSEN Ankylo系列色谱柱 (1)
- SHIMSEN SuperbⅡ系列 (1)
- 尺寸排阻色谱柱 (16)
- 离子交换色谱柱 (12)
- 离子色谱柱 (8)
- SFC色谱柱 (9)
- 液相色谱柱制备柱 (10)
- 流动相杂质捕集柱 (4)
- 液相色谱柱专用柱 (17)
- 其它色谱柱 (5)
- 液相色谱柱保护柱 (35)
- 气相毛细管色谱柱 (42)
- 气相毛细管色谱柱专用柱 (22)
- PLOT及金属气相毛细管色谱柱 (23)
- 气相毛细管色谱柱保护柱 (6)
- 固相萃取柱 (57)
- QuEChERS产品 (9)
- 免疫亲和柱 (13)
- 生物样品前处理 (7)
- 样品前处理相关装置 (3)
- 一步法净化小柱 (2)
- 同位素内标 (2683)
- 混标标准品 (439)
- 仪器试剂标准品 (70)
- 特色标准品试剂 (97)
- 热点项目标准品试剂 (486)
- 过滤产品 (13)
- 样品瓶及溶剂瓶 (22)
- 移液器及分液器 (5)
- 安全防护 (2)
- 进样针 (5)
- 比色皿 (3)
- 石墨管 (4)
- 空心阴极灯 (1)
- 管路及接头 (2)
- 方法包 (18)
- 采样产品 (2)
- 岛津分析仪器选配 (9)
- 实验室通用设备 (6)
- 其他小型仪器设备 (11)
- 微生物检测耗材 (50)
- 细胞培养 (18)
CompactDry 微生物快速测试片使用方法CompactDry 微生物快速测试片应用领域及特点CompactDry 微生物快速测试片采样方式CompactDry 微生物快速测试片沙门氏菌CompactDry 微生物快速测试片自动计数...
登录会员可看价格
CompactDry 微生物快速测试片使用方法CompactDry 微生物快速测试片应用领域及特点CompactDry 微生物快速测试片采样方式CompactDry 微生物快速测试片金黄色葡萄球菌CompactDry 微生物快速测试片自动计数...
登录会员可看价格
货号:066-81012-18中文名:开关英文名:SWITCH,THERMO OHD3-95B使用机型:用于ICPS-8100包装规格:数量1其他参数:维修品,特殊商品,请咨询客服...
登录会员可看价格
货号:066-81012-09中文名:开关英文名:SWITCH,THERMO OHD3-80B使用机型:UV-3600/3600Plus包装规格:1个其他参数:特殊商品请咨询客服...
登录会员可看价格
货号:066-19179-05中文名:计时器英文名:TIMER,H3Y-4 DC24 120S使用机型:用于ICPS-8100包装规格:数量1其他参数:货期较长,请咨询客服...
登录会员可看价格
货号:065-80825-11中文名:继电器英文名:RELAY,MY4 AC100/110使用机型:用于ICPS-8100包装规格:数量1其他参数:3C品,特殊商品,请咨询客服...
登录会员可看价格
货号:065-60823-06中文名:继电器英文名:RELAY,MY4N-D2 DC24V使用机型:用于ICPS-8100包装规格:数量1其他参数:3C品,特殊商品,请咨询客服...
登录会员可看价格
货号:065-43039-02中文名:开关英文名:MAGNETIC SWITCH,SW-0-MAIN AC2*使用机型:用于ICPS-8100包装规格:数量1其他参数:维修品,特殊商品,请咨询客服...
登录会员可看价格
CompactDry 微生物快速测试片使用方法CompactDry 微生物快速测试片应用领域及特点CompactDry 微生物快速测试片采样方式CompactDry 微生物快速测试片菌落总数快速型CompactDry 微生物快速测试片自动计数...
登录会员可看价格
CompactDry 微生物快速测试片使用方法CompactDry 微生物快速测试片应用领域及特点CompactDry 微生物快速测试片采样方式CompactDry 微生物快速测试片肠杆菌科CompactDry 微生物快速测试片自动计数...
登录会员可看价格